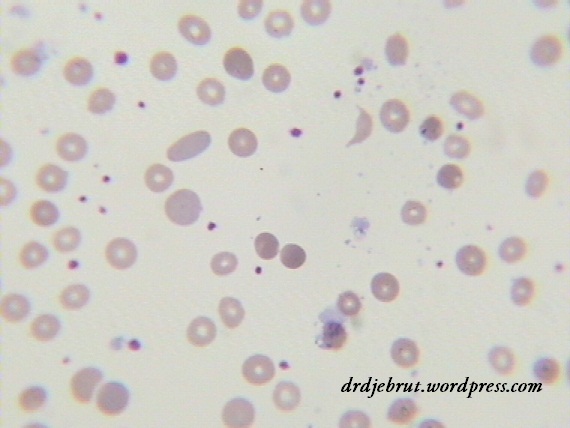
hapusan darah pada AIHA
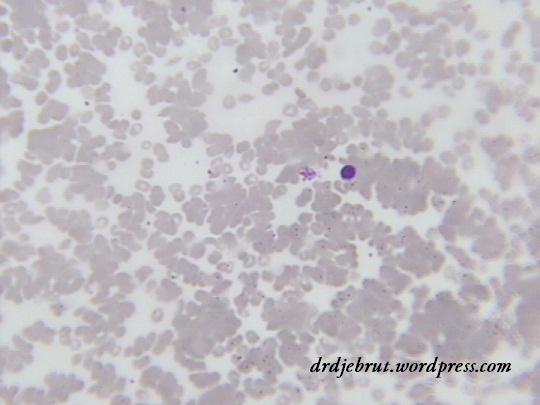
Autoaglutinasi

Hasil Lab pada AIHA atau Anemia Hemolitik Autoimun
AIHA (Autoimmune Hemolytic Anemia) atau anemia hemolitik autoimun merupakan anemia yang disebabkan oleh penghancuran eritrosit oleh autoantibodi. Disebut autoantibodi karena tubuh pasien yang memproduksi antibodi melawan eritrositnya sendiri. Penyebabnya adalah adanya kelainan pada saat pembentukan limfosit, sehingga limfosit yang reaktif terhadap antigen eritrosit tetap terbentuk. Terdapat dua macam tipe dari AIHA ini, yaitu tipe warm dan cold, dengan sekitar 70% kasus merupakan tipe warm. Dalam diagnosis AIHA ini diperlukan temuan klinis atau laboratoris adanya hemolisis (pemecahan eritrosit) dan pemeriksaan serologi autoantibodi.
Gejala yang dirasakan oleh penderita AIHA adalah gejala umum anemia (lemah, letih, lesu), seringkali disertai demam dan jaundice (sakit kuning). Urin berwarna gelap sering ditemukan. Pada pemeriksaan fisik bisa ditemukan tanda-tanda jaundice, pembesaran limpa, pembesaran hati, dan pembesaran kelenjar getah bening.
Selain gejala dan tanda tersebut, terdapat beberapa pemeriksaan laboratorium yang dapat menunjang dalam diagnosis AIHA. Yang pertama perlu diperiksa adalah DL (darah lengkap) dan hapusan darah. Dari DL bisa dilihat adanya penurunan Hb (anemia) dan hematokrit. Penurunan Hb biasanya berat dengan kadar kurang dari 7 g/dl. Kadar trombosit dan leukosit biasanya masih normal. Bisa juga didapatkan peningkatan jumlah retikulosit. Pada hapusan darah dapat ditemukan bentukan eritrosit yang bervariasi (poikilositosis), sferosit, polikromasi dan kadang autoaglutinasi. Pada pemeriksaan kimia darah didapatkan peningkatan bilirubin indirek dan peningkatan kadar LDH. Sedangkan pada urinalisis bisa ditemukan hemoglobinuria.
Hapusan darah pada penderita AIHA
Autoaglutinasi pada hapusan darah tepi
Terdapat beberapa pemeriksaan serologi untuk mendeteksi adanya autoantibodi pada AIHA, diantaranya adalah Direct Antiglobulin Test (DAT, Direct Coombs Test) dan Indirect Antiglobulin Test (IAT, Indirect Coombs Test). Yang biasa dikerjakan adalah DAT yang mendeteksi adanya autoantibodi (IgG) yang menyelubungi eritrosit. Pemeriksaan DAT pada penderita AIHA menunjukkan hasil yang positif, dimana ditemukan aglutinasi eritrosit.
Direct Coomb’s Test
Hasil DAT positif
Yang perlu diperhatikan, tidak semua penderita AIHA menunjukkan semua gambaran laboratorium tersebut. Bisa saja tidak didapatkan peningkatan bilirubin indirek, tidak ditemukan hemoglobinuria, atau malah pemeriksaan DAT menunjukkan hasil yang negatif. Sehingga penentuan diagnosisnya tetap melihat dari anamnesis, pemeriksaan fisik dan pemeriksaan laboratorium yang lain apakah terdapat tanda-tanda hemolisis, juga menyingkirkan penyebab anemia hemolitik yang lain.
Semoga bermanfaat
Sumber: Wintrobe’s Clinical Hematology 12th Edition;
Manual of Clinical Hematology

![[Download] Pedoman Nasional Pelayanan Kedokteran Tata Laksana Thalassemia (KMK)](/content/images/uploads/2022/10/KMK.jpg)
![[Download] Pemeriksaan Laboratorium pada Thalassemia](/content/images/uploads/2022/09/cover-web-scaled.jpg)